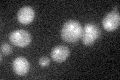
YBR256C
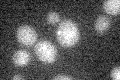
YBR256C

View description
Riboflavin synthase; catalyzes the last step of the riboflavin biosynthesis pathway
Localization:
Intensity:
Fold change:
Significance:
-
C’ GFP library in SD

below threshold16.97 -
N' NOP1pr-GFP in SD

below threshold13.7978 -
N' TEF2pr-mCherry in SD

below threshold7.06944 -
N' NATIVEpr-GFP in SD

below threshold18.9982 -
N' TEF2pr-VC and Cyto-VN in SD

below threshold24.4484 -
C’ GFP library in SD+DTT
cytosol17.231.01No -
C’ GFP library in SD+H2O2

cytosol15.040.88No -
C’ GFP library in Starvation Media
cytosol16.540.97No -
C’ GFP library on the background of Pup2-DaMP

below threshold -
C’ GFP library on the background of CCT mutant

below threshold16.76120.987556No
